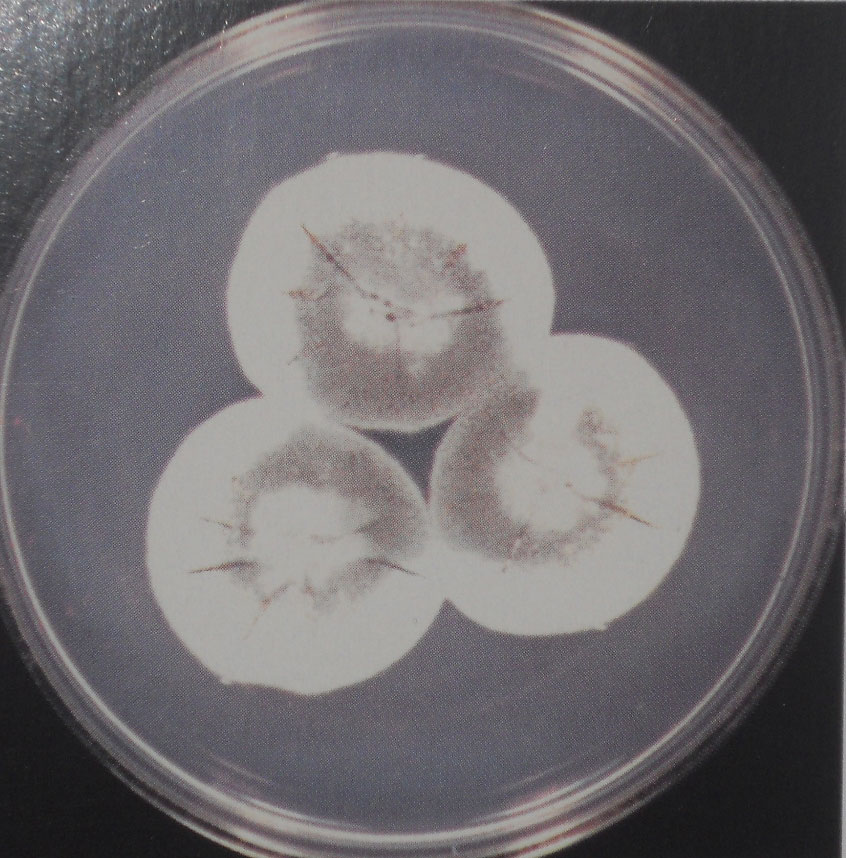
铅色青霉
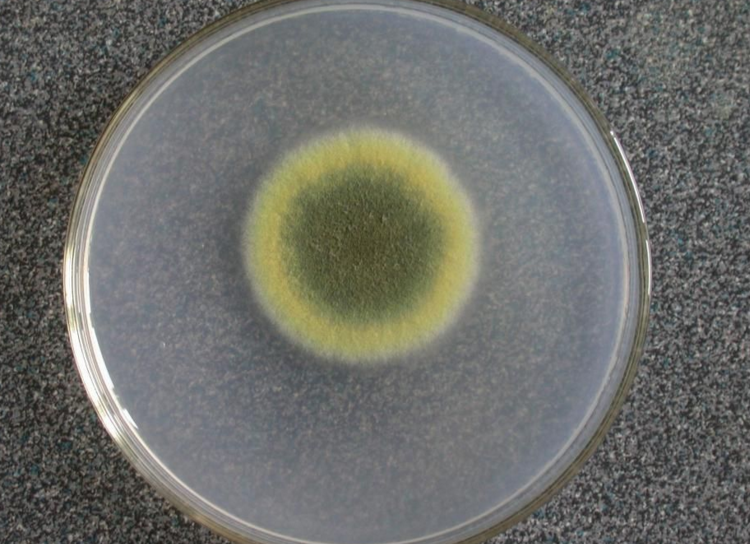
青霉属

青霉菌落形态特征

p>青霉菌属 br>形态与染色: br>除马尔尼菲青霉菌外,青霉菌属菌种
图片尺寸1700x1706
青霉菌
图片尺寸1280x960
香肠表面的青霉菌菌落
图片尺寸1200x801
sabouraud dextrose琼脂上青霉菌菌落
图片尺寸1200x795
sabouraud dextrose琼脂上青霉菌菌落
图片尺寸1200x795
sabouraud dextrose琼脂上青霉菌菌落
图片尺寸1200x800
铅色青霉
图片尺寸846x858
马尔尼菲青霉青霉菌属
图片尺寸1080x1439
香肠表面的青霉菌菌落
图片尺寸1200x801
青霉菌.40倍镜.
图片尺寸1680x1980
青霉属
图片尺寸800x600
青霉属
图片尺寸1152x864
霉菌图谱-产黄青霉菌penicillium chrysogenum
图片尺寸3024x4032
图1-48 青霉菌和曲霉菌菌落特征比较.png
图片尺寸580x328
sabouraud dextrose琼脂上青霉菌菌落
图片尺寸1200x800
543真菌观察青霉和酵母菌
图片尺寸1080x1439
青霉属
图片尺寸750x544
真菌(青霉)纯化问题 - 微生物 - 实验/技术 - 小木虫论坛-学术科研
图片尺寸592x444
青霉属
图片尺寸801x553
绳状青霉在pda上的菌落特征
图片尺寸446x352